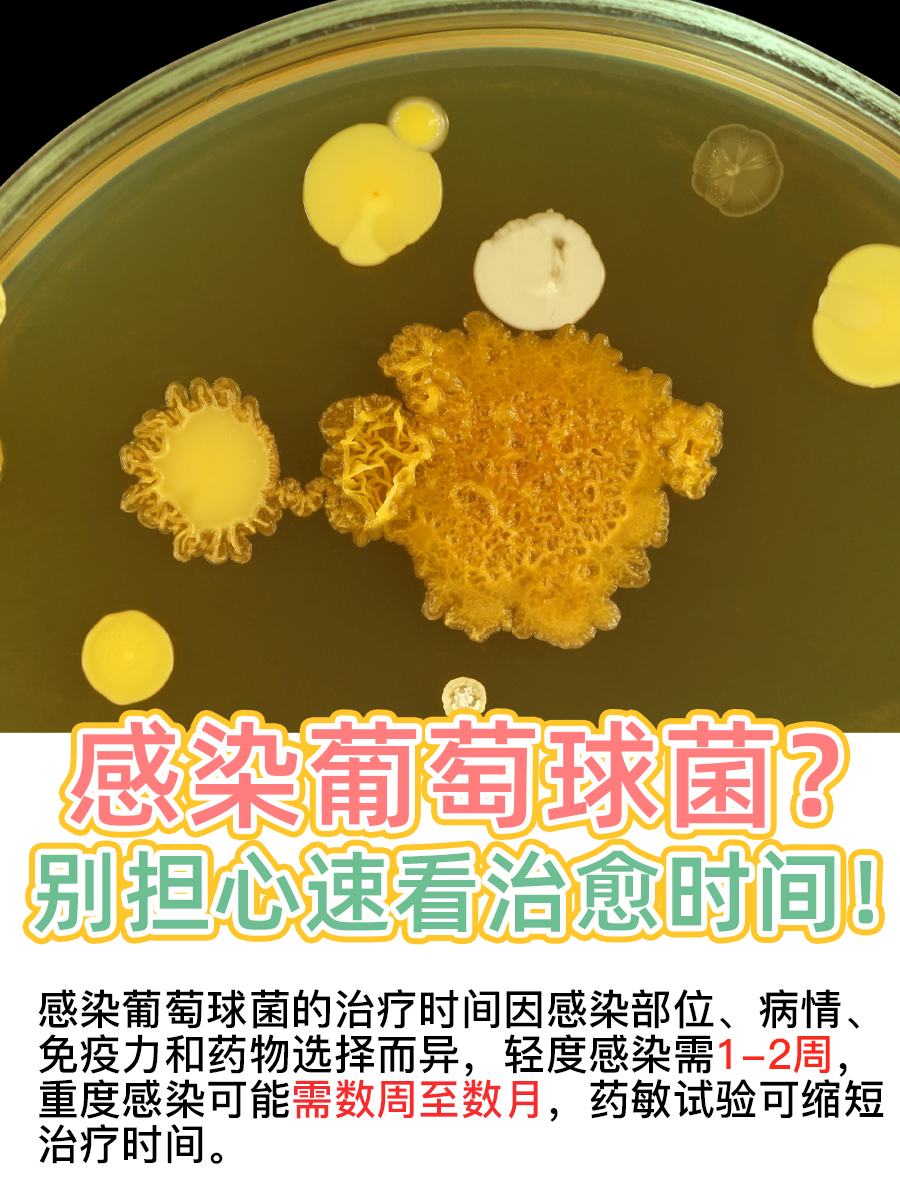
感染葡萄球菌？别担心，速看治愈时间！

👉葡萄球菌是一群常见的革兰氏阳性球菌,因常堆聚成葡萄串状得名。它们广泛分布于自然界,如空气、水、土壤,甚至在人体皮肤、鼻腔、口腔等部位也有定植。大部分葡萄球菌属于条件致病菌,一般情况下不会引发疾病,但当人体免疫力下降,或皮肤黏膜屏障受损时,就可能趁机而入,引发感染。
👀要明确一点:感染葡萄球菌的治疗时间并不是一成不变的。它受到多种因素的影响,包括感染部位、病情轻重、患者免疫力以及所选用的治疗药物等。但一般来说,轻度感染可能需要1-2周的时间,比如皮肤感染等。而重度感染则可能需要数周甚至数月的时间才能完全康复,比如感染了肺部、骨骼等部位。
🌱再者,选择合适的抗生素是治疗葡萄球菌感染的关键。不同的抗生素对葡萄球菌的杀菌效果不同,因此,在治疗前,医生通常会进行药敏试验,以选择最敏感的抗生素进行治疗。这样一来,治疗时间也会相应缩短。
📍因此,在治疗葡萄球菌感染时,需要这么做:
🔹确诊与药敏试验:一旦怀疑感染葡萄球菌,应立即就医进行确诊。医生会通过细菌培养及药敏试验来确定感染的细菌种类及敏感药物。这是制定个性化治疗方案的关键步骤。
🔹抗生素治疗:根据药敏试验结果,医生会选择合适的抗生素进行治疗。常用的抗生素包括青霉素类、头孢菌素类、万古霉素等。需要注意的是,抗生素的使用应遵循医嘱,按时按量服用,切勿自行停药或更改剂量。
此外,针对葡萄球菌感染,还有一些注意事项以及预防再次感染的措施,详细请见图!
👏那么,大家是否曾经感染过葡萄球菌?治疗过程中遇到了哪些困难或疑问?认为哪些方法或药物对治疗葡萄球菌最有效?欢迎在评论区留言分享!